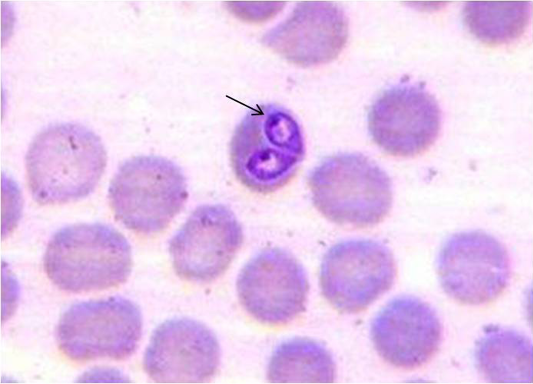
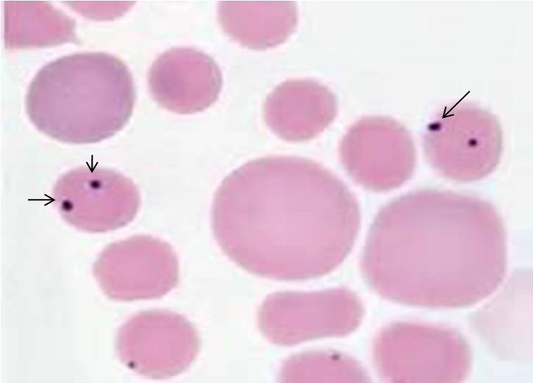

Advances in Animal and Veterinary Sciences
Giemsa stained blood smear showing B.canis (arrow) organism
Giemsa stained blood smear showing B.gibsoni (arrow) organism
Electrophoresis gel (1.0 % agarose), showing lanes L1-100 bp DNA marker, L2- Positive control, L3- Negative control, L4- No template control, L5 to L10- Test samples showing positive PCR product of B.canis (450 bp), L11 to L13- Negative test samples.
Electrophoresis gel (1.0 % agarose, stained with ethidiumbromide), showing lanes L1-100 bp DNA marker, L2- Positive control, L3- Negative control, L4- No template control,L5, L6, L8 & L10- Test samples showing positive PCR product of B.gibsoni (671 bp), L7 & L9- Negative test samples.